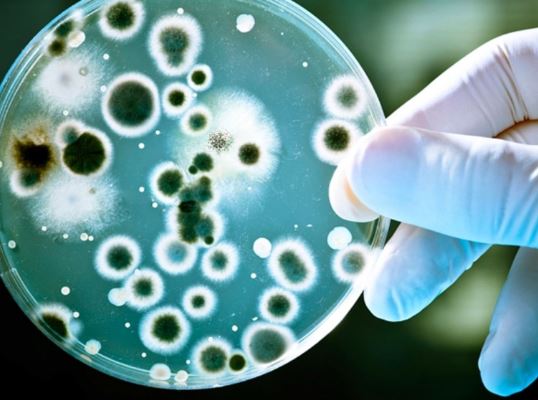

Как построить Дом без рисков?
С 1 марта 2025 года в России действует Федеральный закон №186-ФЗ о строительстве индивидуальных жилых домов (ИЖС) по договорам строительного подряда с использованием счетов эскроу.
Эскроу-счёт — это специальный банковский счёт, который обеспечивает безопасность расчётов между покупателем и продавцом.
Также он известен как условный счёт, поскольку передача средств осуществляется исключительно при выполнении заранее оговорённых условий.
Эскроу – надёжный способ защитить свои деньги.
#администрацияЕйскогорайона #эскроу #строительство
Вакцинация как мера профилактики бруцеллёза
Бруцеллёз - инфекционно-аллергическое заболевание, общее для человека и животных, которое может протекать в острой и хронической форме, с преимущественным поражением опорно-двигательного аппарата, сердечно-сосудистой, нервной и половой систем.
Основными источниками бруцеллезной инфекции для человека являются овцы, козы, крупный рогатый скот, свиньи.
От человека к человеку заболевание не передается.